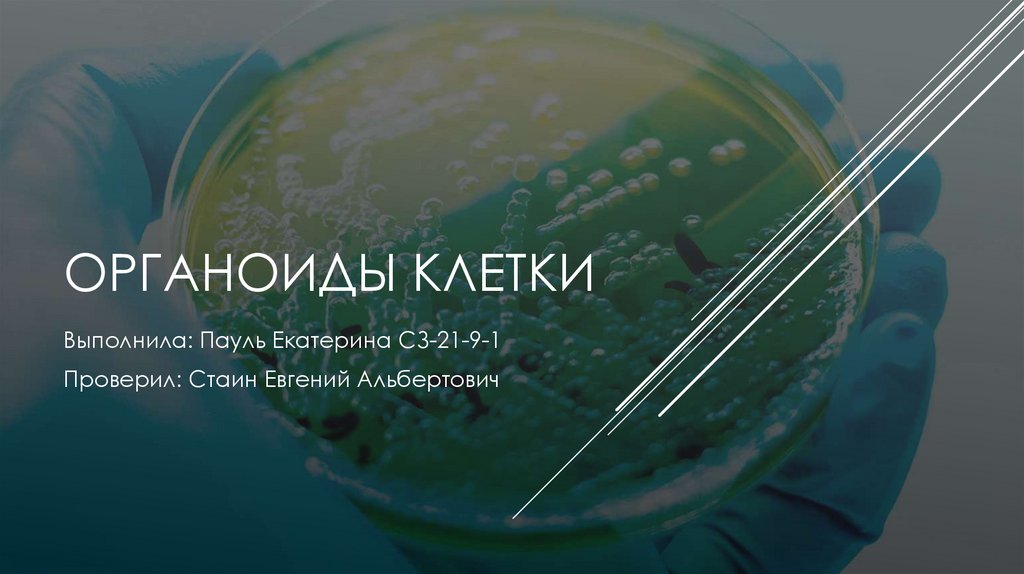
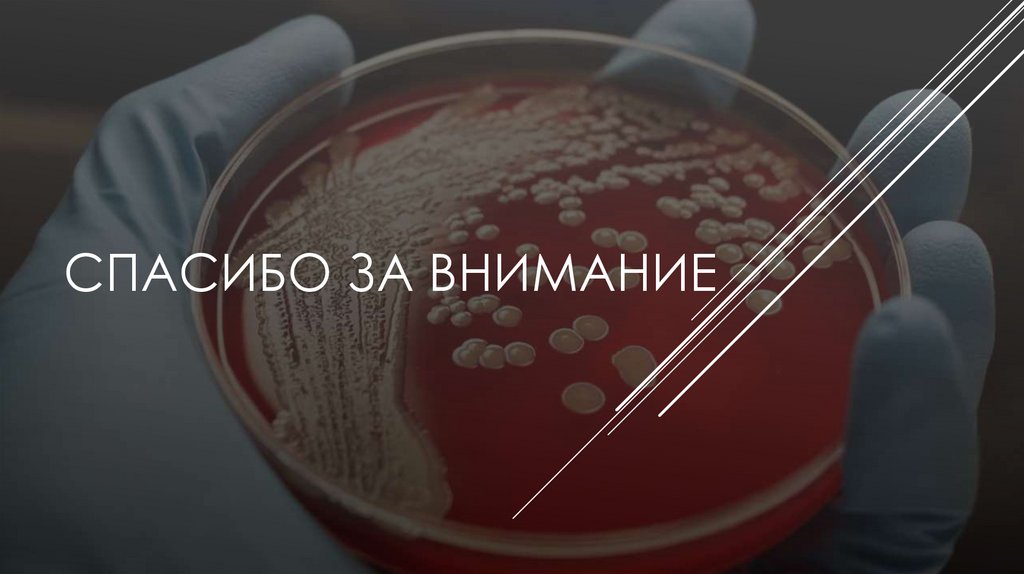

Похожие презентации:
Органоиды клетки
1.
ОРГАНОИДЫ КЛЕТКИВыполнила: Пауль Екатерина СЗ-21-9-1
Проверил: Стаин Евгений Альбертович
2.
ПРОКАРИОТИЧЕСКАЯ КЛЕТКА ЦИАНОБАКТЕРИИФикобилисомы
Тилакоидная
мембрана
Рибосомы
Нуклеотид
(кольцевая ДНК)
Клеточная стенка:
Клеточная мембрана
Пептидогликановый слой
Внешняя мембрана
Слизистая оболочка
Капсула
Тилакоиды
Рибулозобисфосфаткарбоксилаза
Карбоксисома
3.
ЭУКАРИОТИЧЕСКАЯ ЖИВОТНАЯ КЛЕТКАМитохондрия
Ядро
Ядрышко
Шероховатая ЭПС
Рибосома
Лизосома
Аппарат Гольджи
Гладкая ЭПС
Цитоплазма
Пероксисома
Клеточная мембрана
Цитоскелет
Центриоли
4.
ЭУКАРИОТИЧЕСКАЯ РАСТИТЕЛЬНАЯ КЛЕТКАКлеточная стенка
из целлюлозы
Хлоропласт
Клеточная мембрана
Митохондрия
Рибосомы
Цитоскелет
Плазмодесма
Центральная вакуоль
Аппарат Гольджи
Лизосомы
Ядро с ядрышком
ЭПС гладкая и
шероховатая
Цитоплазма
5.
ЭУКАРИОТИЧЕСКАЯ ГРИБНАЯ КЛЕТКАКлеточная мембрана Цитоскелет
Вакуоль
Клеточная стенка
ЭПС гладкая и
шероховатая
Цитоплазма
Запас
питательных
веществ
Рибосомы
Ядро с ядрышком
Лизосома
Митохондрия
Аппарат
Гольджи
6.
ЦИТОСКЕЛЕТ ПлазматическаяЭПС
мембрана
Ядро
Промежуточные
нити
Митохондрия
Рибосомы
Микрофиламенты
Микротрубочка
7.
РИБОСОМАМалая
субъеденица
иРНК
тРНК
Аминокислота
Большая
субъединица
Мембрана
эндоплазматической
сети
Синтезируемая
цепь молекулы
белка
8.
КЛЕТОЧНЫЙ ЦЕНТРДочерняя
Микротрубочка центриоль
Триплет
микротрубочек
Материнская
центриоль
Белковые
мостики
9.
РЕСНИЧКИ И ЖГУТИКИЦентральные
микротрубочки
Дуплеты микротрубочек
10.
Гладкая ЭПСЭПС
Шероховатая ЭПС
Рибосомы
11.
АППАРАТ ГОЛЬДЖИВезикула
Цистерны
Люмен
12.
ЛИЗОСОМАМембрана
Ферменты
Транспортные белки
13.
ВАКУОЛЬКлеточный сок
14.
ВЕЗИКУЛАЛипидный слой
15.
ПЕРОКСИСОМАЛипидный слой
Плазматическая
мембрана
16.
КАРБОКСИСОМАРуБисКО
Карбоангидразы
Белковая оболочка
17.
ЯДРО18.
ПЛАСТИДЫ19.
ПЛАСТИДЫ20.
МИТОХОНДРИЯ21.
ЛИТЕРАТУРАКалькуляторы онлайн, справочник энциклопедия
Биология - наука о жизни
ЯКласс
Библиотека видеоуроков по школьной программе ИнтернетУрок
Большая российская энциклопедия - электронная версия
Всё для студентов
SiteKid.ru - детская энциклопедия
Словари и энциклопедии на Академике
Википедия - свободная энциклопедия
PubMed
National Center for Biotechnology Information
Российская электронная школа
Studarium, лучшая онлайн подготовка к ЕГЭ по биологии и химии
Open Science Wiki - Fandom
Создаём будущее агробизнеса!

Биология
Биология








